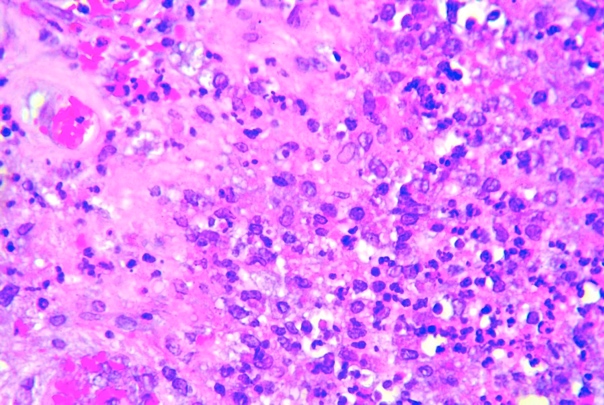

Resumen
Objetivo
Caracterizar las membranas periprotésicas de cadera en base a la clasificación de Morawietz, mediante análisis histopatológico y bacteriológico.
Material y Métodos
Se obtuvieron un total de 44 muestras correspondientes a membranas periprotésicas de cadera, realizando un análisis histopatológico y clasificación morfológica de las membranas de acuerdo a los criterios propuestos por Morawietz, así como análisis bacteriológico mediante cultivo de membranas periprotésicas de cadera en pacientes sometidos a retiro de prótesis de cadera.
Resultados
Del total de 44 muestras obtenidas, 12 membranas periprotésicas (27%) fueron del tipo I inducida por partículas de desgaste, 16 muestras (36%) del tipo II infecciosa, 6 (13%) del tipo III combinado y 10 (22%) del tipo IV indeterminado. El promedio de tiempo entre la artroplastia primaria y la cirugía de revisión difirió según el tipo de membrana, siendo 7 años para la membrana tipo I, 4 años para la tipo II, 5 años en la tipo III y también 5 años en la tipo IV. El Staphylococcus aureus (n=6) fue el agente patógeno más común, con un total de 11 pacientes en los que se obtuvieron cultivos positivos, el resto de las muestras se reportaron con cultivos sin desarrollo (n=33).
Conclusión
La clasificación de membranas periprotésicas propuesta por Morawietz y colaboradores, brinda una herramienta descriptiva estandarizada, abriendo campo para estudios experimentales de la causa de aflojamiento protésico.
Abstract
Objective
To characterize the periprosthetic hip membranes based on Morawietz classification by histopathological and bacteriological analysis.
Material and Methods
A total of 44 samples were obtained corresponding to periprosthetic hip membranes, performing a histopathological analysis and morphological classification of the membranes according to the criteria proposed by Morawietz, as well as bacteriological analysis by culture of periprosthetic hip membranes in patients who underwent revision surgery.
Results
Of the total of 44 samples obtained, 12 periprosthetic membranes (27%) were of the wear particle induced type (Type I), 16 samples (36%) of infectious type (Type II), 6 (13%) Type III combined, and 10 (22%) of undetermined type (Type IV). The mean time between primary arthroplasty and revision surgery differed according to the type of membrane, with 6.8 years for type I membrane, 3.7 years for type II, 5.4 years for type III and 5.1 years for type IV, respectively. Staphylococcus aureus (n = 6) was the most common pathogen, with a total of 11 patients in which positive cultures were obtained, the rest of the samples were reported with cultures without development (n = 33).
Conclusion:
The classification of periprosthetic membranes proposed by Morawietz et al, provides pathologists and the orthopedic physicians a standardized descriptive tool, opening the field for experimental studies of the cause of prosthetic loosening.
Palabras clave: cadera, biofilm, infección, prótesis
Keywords: hip, biofilm, infection, prostheses and implants
Introducción
Los implantes ortopédicos forman “membranas” de biofilm desde 0,1 hasta 1mm de espesor. Estas membranas son fácilmente extraídas durante los procedimientos quirúrgicos ortopédicos y son susceptibles de análisis histopatológico. La membrana se encuentra localizada en la interfase hueso-material de osteosíntesis, o en los casos de reemplazos articulares totales, entre el hueso y el cemento (1)(2). La etapa inicial del proceso de formación del biofilm es la adherencia sobre la superficie. Una vez que la bacteria se ha adherido a la superficie, comienza a dividirse y las células hijas se extienden alrededor del sitio de unión, formando una microcolonia similar a lo que ocurre durante el proceso de formación de colonias en placas de agar (3- 5). Los biofilms sobre implantes médicos pueden estar compuestos por bacterias Gram positivas, Gram negativas o levaduras. Estos microorganismos proceden de la piel del propio paciente, del personal sanitario o del ambiente. Pueden estar formados por una única especie o por múltiples especies, dependiendo del implante y de la duración de su uso en el paciente. Cuando un implante se contamina con bacterias, son varios los factores que influyen en su desarrollo; inicialmente los microorganismos deben adherirse a la superficie del implante el tiempo suficiente para que la adherencia sea irreversible. Esta adherencia depende del flujo de líquido al que está sometido el implante, del número de bacterias que se adhieren, de las características físico-químicas del implante y de la respuesta inmune del huésped (6 – 8).
Una vez que la bacteria se ha adherido a la superficie del implante y ha formado el biofilm, éste actúa como una fuente de infección sobre todo en pacientes inmunocomprometidos. Los mecanismos por los que el biofilm produce los síntomas de la enfermedad todavía no están completamente establecidos, pero se ha sugerido que las bacterias del biofilm pueden producir endotoxinas, se pueden liberar grupos de bacterias al torrente sanguíneo, se vuelven resistentes a la acción fagocitaria de las células del sistema inmune que, por otro lado, constituyen un nicho para la aparición de bacterias resistentes a los tratamientos antibióticos (9 -11).
Morawietz et al. (12) propusieron una nueva clasificación para la evaluación y análisis del tejido periprotésico, con el objetivo de obtener criterios para definir los tipos de membranas y facilitar el diagnóstico histopatológico de rutina. Morawietz et al., (12) (13) describieron cuatro tipos de membranas periprotésicas. La membrana tipo I, inducida por partículas de desgaste. Se caracteriza por la presencia de partículas de cuerpo extraño, abundantes macrófagos y células gigantes multinucleadas en al menos 20% del tejido. Se pueden identificar partículas de metil metacrilato, dióxido de zirconio o sulfato de bario (Figura 1). La tipo II o infecciosa que se observa la presencia de tejido de granulación con abundantes leucocitos neutrófilos y células plasmáticas, sin partículas de cuerpo extraño (Figura 1). La membrana tipo III o combinada pues Contempla aspectos del tipo I y II en forma simultánea (Figura 1) y la tipo IV o indeterminada ya que muestra parámetros morfológicos diferentes a la tipo I y la tipo II, con mayor presencia de abundantes fibras de colágena, fibrina, fibroblastos y macrófagos (Figura 1). El objetivo de este estudio está encaminado a caracterizar las membranas periprotésicas de cadera en base a la clasificación de Morawietz, mediante análisis histopatológico y bacteriológico.
Figura 1
A) Preparación histológica de membrana periprotésica de cadera tipo I, con macrófagos y células gigantes multinucleadas de tipo cuerpo extraño, partículas de material protésico
B) membrana periprotésica de cadera Tipo II, con tejido de granulación, fibroblastos, proliferación de vasos, edema, infiltrado inflamatorio de predominio neutrófilos.
C) membrana periprotésica de cadera Tipo III, con reacción a partículas de material protésico y reacción inflamatoria con neutrófilos.
D) membrana periprotésica de cadera Tipo IV con tejido conectivo poco celular rico en colágena, fibrina en la superficie, macrófagos y fibroblastos y sscasos neutrófilos (tinción hematoxilina-eosina, x10)
Material y métodos
Tipo de estudio: Investigación aplicada, serie casos, prospectivo y descriptivo. El presente estudio se realizó en el Hospital de Ortopedia “Dr. Victorio de la Fuente Narváez” con el apoyo de los servicios de Rescate Osteoarticular y Reemplazos Articulares. Se recolectaron un total de 44 muestras correspondientes a membranas periprotésicas de cadera obtenidas durante el transquirúrgico de pacientes a quienes se les realizó retiro de prótesis de cadera durante 9 meses de recolección. De acuerdo a los objetivos planteados, en el Departamento de Anatomía Patológica se evaluó el tipo de membrana periprotésica.
Clasificación histológica
Las muestras de membranas periprotésicas se obtuvieron durante el transquirúrgico de pacientes con diagnóstico de aflojamiento protésicos sépticos y asépticos de cadera, programados para retiro de prótesis de cadera cementadas y no cementadas. Una sección de las muestras fué colocada de manera inmediata en formalina al 10%, evitando desecación del mismo, y trasladada al departamento de anatomía patológica para el procesamiento, donde la evaluación histopatológica se realizó de alta resolución en muestras teñidas con hematoxilina y eosina convencional, posteriormente se efectuó el análisis histopatológico correspondiente.
La evaluación histopatológica se llevó a cabo por 2 observadores (médicos anatomopatólogos con experiencia en el campo), de manera independiente en estudio cegado. Para el análisis morfológico, se utilizó la clasificación histopatológica de Morawietz et al., (12) (13). Del total de las muestras que cumplieron con los criterios de selección, el 55% correspondieron a mujeres y el 45% a hombres. El rango de edad de los pacientes sometidos a retiro de prótesis de cadera fue de 41 a 89 años, con un promedio de edad de 65 años.
>Estudio bacteriológicoPara el análisis microbiológico se obtuvo una muestra por raspado de la membrana periprotésica, la cual fué colocada inmediatamente en medio de transporte, y trasladada a laboratorio clínico para el análisis correspondiente, que incluyó cultivo para microorganismos. El presente estudio no puso en peligro la integridad del paciente y se apegó estrictamente a las Normas y Reglamentos vigentes de Investigación en Salud en Seres Humanos.
Para el análisis estadístico se utilizó el método p Spearman.
Resultados
Del total de 44 muestras obtenidas, 12 membranas periprotésicas (27%) fueron del tipo I, inducida por partículas de desgaste, 16 muestras (36%) del tipo II infecciosa, 6 (13%) del tipo III combinado y 10 (22%) del tipo IV indeterminado (Tabla 1) (Figura 2).
Tabla 1: Frecuencia de la clasificación histológica de las membranas periprotésicas en base a la clasificación de Morawietz et al., (12)
|
Tipo de Membrana |
Frecuencia (n) |
Porcentaje (%) |
|
I |
12 |
27,3 |
|
II |
16 |
36,4 |
|
III |
6 |
13,6 |
|
IV |
10 |
22,7 |
Se correlacionó el tipo de membrana periprotésica y la vida media del componente protésico en años. El promedio de tiempo entre la artroplastia primaria y la cirugía de revisión difirió según el tipo de membrana, siendo 7 años para la membrana tipo I, 4 años para la tipo II, 5 años en la tipo III y tipo IV. Las diferencias en la vida media del componente protésico en correlación con el tipo histológico de la membrana no fue estadísticamente significativo (p=0.091 por análisis univariado).
Bacteriología y tipos de membranas
Los registros microbiológicos fueron disponibles para 44 casos, de los cuales 11 casos (25%) mostraron crecimiento bacteriano en un medio de cultivo. En 9 casos, la infección fue causada por un único patógeno, y en 2 casos la infección fue causada por múltiples patógenos. El Staphylococcus aureus fue el agente patógeno más común, con un total de 11 pacientes en los que se obtuvieron cultivos positivos, el resto de las muestras se reportaron con cultivos sin desarrollo (n=33) (Tabla 2) (Figura 2). En 15 casos, los resultados histopatológicos fueron positivos en comparación con los hallazgos microbiológicos: de éstos 33 casos, el análisis histopatológico resultó tipo II en 11 casos y tipo III en 4 casos, reportándose sin desarrollo bacteriano. Obtuvimos un coeficiente de correlación no estadísticamente significativo (p=0,132) entre el diagnóstico histopatológico y bacteriológico.
Tabla 2: Agentes causales más frecuentes encontrados en cultivos de membranas periprotésicas
|
Microorganismo aislado |
Casos |
Porcentaje (%) |
|
Sin desarrollo |
33 |
75 |
|
Staphylococcus aureus |
6 |
14 |
|
Pseudomona aeruginosa |
1 |
2,2 |
|
Klebsiella pneumoniae |
1 |
2,2 |
|
Corynebacterium amycolatum |
1 |
2,2 |
|
Escherichia coli |
1 |
2,2 |
|
Cedecea davisae |
1 |
2,2 |
|
|
|
|
|
TOTAL |
44 |
100 |
Discusión
En nuestro estudio, a diferencia de los resultados de este autor, la membrana periprotésica del Tipo II Infecciosa fue la más frecuente en un 36%. Esta membrana se caracterizó por la presencia de proceso inflamatorio agudo acentuado con extensa necrosis, tejido de granulación y reacción tipo cuerpo extraño, fibrosis. El tipo de membrana de acuerdo a nuestros resultados, no se correlaciona significativamente con la vida media del componente protésico. Sin embargo, se observó una menor duración del implante en la membrana periprotésica tipo II y una mayor duración en la membrana tipo I, que corresponde a un aflojamiento más temprano del implante cuando hay un proceso infeccioso. Por otra parte, no observamos correlación significativa entre el tipo de membrana periprotésica y los hallazgos microbiológicos. Por lo que creemos que este sistema de clasificación puede ser adecuado tanto para los patólogos y quirúrgicos, como una herramienta diagnostica estandarizada para la tipificación de estas lesiones.
Las membranas tipo II y III se relacionaron más frecuente al desarrollo de colonias bacterianas, en las cuales predominó Staphylococcus aureus, que corresponde al patógeno más común reportado en nuestra unidad. Morawietz et al., (12) a diferencia de nuestros resultados, reportaron el mayor número de casos asociados a Staphylococcus coagulasa negativo y epidermidis. Sin embargo, se encontró una discrepancia entre los hallazgos microbiológicos e histológicos. En bacteriología, los reportes negativos pueden resultar de una serie de factores como tiempo insuficiente de incubación, inadecuado medio de cultivo o terapia previa del paciente con antibióticos. La detección de desarrollo de crecimiento bacteriano puede resultar de la contaminación de la muestra por flora bacteriana normal. Estos problemas, reducen el nivel de significancia de los medios de cultivos bacterianos.
Los cultivos intraoperatorios, aunque son considerados el patrón de referencia, pueden ser negativos en algunos casos de infección periimplante clínicamente probada, en estos casos conducen a errores diagnósticos, por lo que el cirujano puede apoyarse en estudios histopatológicos o de ser posible en estudios moleculares.
El diagnóstico de infección periprotésica continúa siendo un problema actualmente, pues no existe ninguna modalidad diagnóstica única con sensibilidad y especificidad absolutas. El diagnóstico exacto exige una combinación de pruebas y una firme sospecha clínica (14)(15). El diagnóstico histopatológico es clínicamente relevante, ya que en el caso de la infección periprotésica, el éxito de la cirugía de revisión depende en cierta medida de la elección de la estrategia del reemplazo, ya sea en uno o dos tiempos quirúrgicos, o el diferimiento quirúrgico de 4 a 6 meses, y del tratamiento antibiótico eficiente durante el tiempo suficiente (16-18). Los estudios bacteriológicos por sí solos no logran detectar el patógeno en todos los casos, y los resultados positivos son posibles debido a la contaminación de las muestras. En cambio, la infección periprotésica puede probarse mediante toma de muestras y procesamiento de las mismas durante la cirugía de revisión, por lo que la estrategia del manejo quirúrgico puede ser modificada en el transquirúrgico si es necesario.
La determinación de los tipos de membranas periimplante según la clasificación de Morawietz, depende en gran medida de la experiencia del patólogo que interpreta los cortes, además de la calidad metodológica de obtención de las muestras aplicada por el cirujano. La estrecha comunicación entre el cirujano ortopedista y patólogo, permite al equipo médico establecer sus propios umbrales de decisión. En el futuro, los nuevos métodos moleculares apoyarán el diagnóstico de las infecciones periimplante de forma más certera, además de dar una mejor definición diagnóstica.
La clasificación de membranas periprotésicas propuesta por Morawietz y colaboradores, brinda a los patólogos y al médico ortopedista una herramienta descriptiva estandarizada para estas lesiones. En particular, la cuestión de si el aflojamiento es debido a una infección bacteriana o no, se puede responder en la mayoría de los casos, por lo que esta clasificación es una pauta tanto para el diagnóstico como para el tratamiento, y en combinación con otros métodos diagnósticos, nos ofrece una mayor seguridad en la toma de decisiones.
Agradecimientos
Este trabajo fue llevado a cabo gracias a la colaboración del personal de médicos adscritos de los servicios de Rescate Osteoarticular y Reemplazos Articulares, así como en la contribución de revisión y redacción por el Dr. Rubén Torres, Director de Educación e Investigación de la UMAE “Dr. Victorio de la Fuente Narváez”.
Referencias
- Otero J, Baños R. González L. Quartz tuning fork studies on the surface properties of Pseudomonas aeruginosa during early stages of biofilm formation. Colloids and Surfaces B: Biointerfaces. 2013; 102:117-23.
- Vila J, Sorian A, Mensa J. Bases moleculares de la adherencia microbiana sobre los materiales protésicos; Papel de las biocapas en las infecciones asociadas a los materiales protésicos. Enferm Infecc Microbiol Clin. 2008; 26:48-55.
- Miner A, Losina E, Katz J. Deep infection after total knee replacement: Impact of laminar airflow systems and body exhaust suits in the modern operating room. Infect Control Hosp Epidemiol. 2007; 28:222-6.
- Florian C, Alvarado D, Loha J. Evaluación in vitro de la resistencia a ciprofloxacino en biopelículas y poblaciones planctónnicas de pseudomonas aeruginosa de origen hospitalario. An Fac Med Lima. 2006; 67:290-7.
- Kabayashi N, Bauer TW, Tuohy M, Fujishiro T. Brief ultrasonication improves detection of biofilm – formative bacteria around a metal implant. Clin Orthop Relat Res. 2007; 457:210-3.
- Ha KY, Chung YG, Ryoo SJ. Adherence and biofilm formation of staphylococcus epidermidis and mycobacterium tuberculosis on various spinal implants. Spine. 2005; 30:38-43
- Barcat JA. Biofilms. Medicina (Buenos Aires) 2005; 65: 369-72.
- Neut D, Hendriks JG, van Horn JR, an der Mei HC, Busscher HJ. Pseudomonas aeruginosa biofilm formation and slime excretion on antibiotic to aded bone cement. Acta Orthop. 2005; 76:109-14.
- Stoodley P, Ehrlich GD, Sedghizadeh PP, Hall-Stoodley L,Baratz ME,Altman DT, et al. Orthopaedic biofilm infections. Curr Orthop Pract. 2011; 22:558–63.
- Balaban N, Stoodley P, Fux CA, Wilson S,Costerton JW,Dell'Acqua G. Prevention of staphylococcal biofilm-associated infections by the quorum sensing inhibitor RIP. Clin Orthop Relat Res. 2005; 437:48-54.
- Ehrlich GD, Stoodley P, Kathju S, Zhao Y, McLeod BR, Balaban N, et al. Engineering approaches for the detection and control of orthopaedic biofilm infections. Clin Orthop Relat Res. 2005; 437:59-66.
- Morawietz L, Classen RA, Schröder JH, Dynybil C, Perka C, Skwara A, et al. Proposal for a histopathological consensus classification of the periprosthetic interface membrane. J Clin Pathol. 2006; 59:591-7.
- Gallo J, Lužná P, Holinka M, Ehrmann J,Zapletalová J,Lošták J. Validity of the Morawietz classification for evaluation of periprosthetic tissue. Acta Chir Orthop Traumatol Cech. 2015; 82:126-34.
- Ariza J, Gorane E, Murillo O. Infecciones relacionadas con las prótesis articulares. Enferm Infecc Microbiol Clin. 2008; 26:380-90.
- Parvizi J, Ghanem E, Menashe S, Parvizi J, Ghanem E, Menashe S. Periprosthetic infection: what are the diagnostic challenges? J Bone Joint Surg (Am). 2006; 88-A:138-47.
- García A, Hernando de la Raivendi C, Muñoz L. Reacciones alérgicas/inmunológicas a materiales empleados en Cirugía Ortopédica y Traumatología. I. Materiales internos. Patologia del Aparato locomotor 2004; 2:114-25.
- Feeman B. Microbiología de Burrows. Madrid: Interamericana; 22ª ed, 1996: 57-62.
- Parvizi J, Zmistowski B, Berbari E, Bauer TW, Springer BD, Della Valle CJ, et al. New Definition for Periprosthetic Joint Infection: From the Workgroup of the Musculoskeletal Infection Society. Clin Orthop Relat Res. 2011; 469:2992-4.